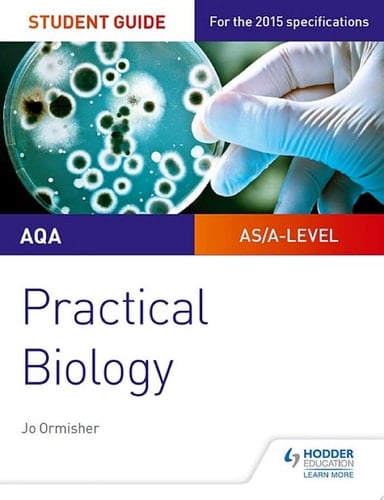
AQA A-level Biology Student Guide: Practical Biology

Exam Board: AQA Level: AS/A-level Subject: Biology First Teaching: September 2015 First Exam: June 2016 Ensure your students get to grips with the core practicals and develop the skills needed to succeed with an in-depth assessment-driven approach that builds and reinforces understanding; clear summaries of practical work with sample questions and answers help to improve exam technique in order to achieve higher grades. Written by an experienced teacher, this Student Guide for practical Biology: - Help students easily identify what they need to know with a concise summary of required practical work examined in the A-level specifications. - Consolidate understanding of practical work, methodology, mathematical and other skills out of the laboratory with exam tips and knowledge check questions, with answers in the back of the book. - Provide plenty of opportunities for students to improve exam technique with sample answers, examiners tips and exam-style questions. - Offer support beyond the Student books with coverage of methodologies and generic practical skills not focused on in the textbooks.
Page Count:
96
Publication Date:
2017-07-24
ISBN-10:
1471885607
ISBN-13:
9781471885600
No comments yet. Be the first to share your thoughts!